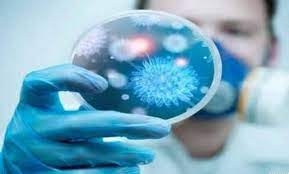
علماء يابانيون يعثرون على

علماء يابانيون يعثرون على "مركز الحب" بالدليل !!!!
السبت, 26 آذار 2022 الساعة 13:05 | منوعات, منوعات
جهينة نيوز
مهما قالوا عن القلب أو الروح فيجب على المرء أن يفهم أن الحب يولد في الدماغ ولكن أين بالضبط؟
أشار العالمان اليابانيان ريوهاي ويدا و نوبوخيتو آبي من جامعة كيوتو إلى منطقة صغيرة في الدماغ يعتقدان أنها "مركز للحب".
والمنطقة التي حددها العالمان اليابانيان صغيرة وتقع في ما يسمى بالنواة المتكئة للدماغ (النواة المتكئة) هنا حيث تشارك خلايا الأعصاب في العديد من العمليات العقلية ونتيجة لذلك يحصل الناس على المتعة و يدمنون على شيء ما ويُعجبون ويحزنون ويخافون ويغضبون ويفرحون.
"مركز الحب" الذي يُفترض أنه مركّب في تلك النواة يتشكل أولا ثم يحافظ على المشاعر الرومانسية (الغرامية) ويتخذ قرار "الحب أو عدم الحب" على أساس المعلومات التي تأتي من الحُصين وقشرة الفص الجبهي واللوزة.
واستطاع اليابانيان إدراك التكوين ومبدأ تشغيل آلية الحب المخفية في الدماغ بفضل التصوير الوظيفي بالرنين المغناطيسي الذي أظهر أي أجزاء من الدماغ تصبح نشطة.
وتضمنت التجارب التي أجراها اليابانيان على 46 رجلا من ذوي الميول الجنسية العادية تتراوح أعمارهم بين 20 و 29 عاما وأعلنوا أنهم كانوا في علاقة عاطفية.
وقام المشاركون بحل الألغاز المنطقية وحصلوا على نوع من "المكافأة" مقابل إجابات صحيحة وعُرض على البعض وجوه شريكاتهم الفرحات وقام العالمان بإعداد صور مناسبة مسبقا وعُرض على الآخرين صورا لنساء غير معروفات وجذابات جنسيا مبتهجات أيضا.
استجابت النواة المتكئة لجميعهن لكن نشاطا واضحا نشأ فيها على مرأى من يحبونهن. وغالبا حتى قبل ذلك أما النساء غير المعروفات فكان نشاط النواة المتكئة ضعيفا.
نتيجة لذلك فإن العالميْن قررا أنهما رصدا عمل "مركز الحب".
أخبار ذات صلة
جهينة نيوز
مهما قالوا عن القلب أو الروح فيجب على المرء أن يفهم أن الحب يولد في الدماغ ولكن أين بالضبط؟
أشار العالمان اليابانيان ريوهاي ويدا و نوبوخيتو آبي من جامعة كيوتو إلى منطقة صغيرة في الدماغ يعتقدان أنها "مركز للحب".
والمنطقة التي حددها العالمان اليابانيان صغيرة وتقع في ما يسمى بالنواة المتكئة للدماغ (النواة المتكئة) هنا حيث تشارك خلايا الأعصاب في العديد من العمليات العقلية ونتيجة لذلك يحصل الناس على المتعة و يدمنون على شيء ما ويُعجبون ويحزنون ويخافون ويغضبون ويفرحون.
"مركز الحب" الذي يُفترض أنه مركّب في تلك النواة يتشكل أولا ثم يحافظ على المشاعر الرومانسية (الغرامية) ويتخذ قرار "الحب أو عدم الحب" على أساس المعلومات التي تأتي من الحُصين وقشرة الفص الجبهي واللوزة.
واستطاع اليابانيان إدراك التكوين ومبدأ تشغيل آلية الحب المخفية في الدماغ بفضل التصوير الوظيفي بالرنين المغناطيسي الذي أظهر أي أجزاء من الدماغ تصبح نشطة.
وتضمنت التجارب التي أجراها اليابانيان على 46 رجلا من ذوي الميول الجنسية العادية تتراوح أعمارهم بين 20 و 29 عاما وأعلنوا أنهم كانوا في علاقة عاطفية.
وقام المشاركون بحل الألغاز المنطقية وحصلوا على نوع من "المكافأة" مقابل إجابات صحيحة وعُرض على البعض وجوه شريكاتهم الفرحات وقام العالمان بإعداد صور مناسبة مسبقا وعُرض على الآخرين صورا لنساء غير معروفات وجذابات جنسيا مبتهجات أيضا.
استجابت النواة المتكئة لجميعهن لكن نشاطا واضحا نشأ فيها على مرأى من يحبونهن. وغالبا حتى قبل ذلك أما النساء غير المعروفات فكان نشاط النواة المتكئة ضعيفا.
نتيجة لذلك فإن العالميْن قررا أنهما رصدا عمل "مركز الحب".
اقرأ المزيد...

 سيريتل تعلن تعيين رئيس تنفيذي جديد وتجديد مجلس الإدارة سيريتل
سيريتل تعلن تعيين رئيس تنفيذي جديد وتجديد مجلس الإدارة سيريتل  أفعى تلدغ رجلاً في كرواتيا فتموت هي بجرعة قاتلة من الكحول
أفعى تلدغ رجلاً في كرواتيا فتموت هي بجرعة قاتلة من الكحول  أكساد تبحث آفاق التعاون المشترك مع جمعية أصدقاء جايكا
أكساد تبحث آفاق التعاون المشترك مع جمعية أصدقاء جايكا  أكساد تشارك في إطلاق الاستراتيجية الوطنية للزراعة السورية 2026–2030
أكساد تشارك في إطلاق الاستراتيجية الوطنية للزراعة السورية 2026–2030  أكساد تختتم دورة متخصصة لإنتاج غراس زيتون سليمة وراثياً في محطة بحوث بوقا باللاذقية
أكساد تختتم دورة متخصصة لإنتاج غراس زيتون سليمة وراثياً في محطة بحوث بوقا باللاذقية  5 دول عربية ضمن قائمة البلدان الأكثر فسادا في العالم في تقرير منظمة الشفافية السنوي
5 دول عربية ضمن قائمة البلدان الأكثر فسادا في العالم في تقرير منظمة الشفافية السنوي  روسيا تكشف لأول مرة عن راجمة الصواريخ سارما في معرض الدفاع العالمي 2026 بالرياض
روسيا تكشف لأول مرة عن راجمة الصواريخ سارما في معرض الدفاع العالمي 2026 بالرياض  محاولة تهريب نيزك بقيمة 5 ملايين دولار من روسيا إلى بريطانيا
محاولة تهريب نيزك بقيمة 5 ملايين دولار من روسيا إلى بريطانيا  باحثون صينيون يعثرون على أقدم أدبيات عن الخيول
باحثون صينيون يعثرون على أقدم أدبيات عن الخيول  سريلانكا تكشف عن أكبر ياقوتة في العالم
سريلانكا تكشف عن أكبر ياقوتة في العالم  السعودية تشيد بدور أكساد في دعم الأمن الغذائي العربي
السعودية تشيد بدور أكساد في دعم الأمن الغذائي العربي  وزير الزراعة السوري يشيد بدور أكساد في الأمن الغذائي العربي لمواجهة تحديات المناخ علي القطاع
وزير الزراعة السوري يشيد بدور أكساد في الأمن الغذائي العربي لمواجهة تحديات المناخ علي القطاع  مبادرة للطاقة الشمسية من الآغا خان تعزز حياة سكان ريف طرطوس
مبادرة للطاقة الشمسية من الآغا خان تعزز حياة سكان ريف طرطوس  الصين تطلق أول ناقلة نفط خام ذكية في العالم تعمل بالميثانول
الصين تطلق أول ناقلة نفط خام ذكية في العالم تعمل بالميثانول  منظمة أكساد تختتم مشاركتها في معرض الزيتون بإدلب وتبرز خبراتها في دعم الزراعة المستدامة
منظمة أكساد تختتم مشاركتها في معرض الزيتون بإدلب وتبرز خبراتها في دعم الزراعة المستدامة  أستون فيلا الإنكليزي يتغلب على مضيفه ليل الفرنسي في ثمن نهائي الدوري الأوروبي
أستون فيلا الإنكليزي يتغلب على مضيفه ليل الفرنسي في ثمن نهائي الدوري الأوروبي
 وزارة التربية: إيقاف الامتحان المتمم لمعادلة الشهادات الأجنبية للطلاب السوريين لعامين
وزارة التربية: إيقاف الامتحان المتمم لمعادلة الشهادات الأجنبية للطلاب السوريين لعامين
 الجيش الأمريكي: مقتل 4 من أصل 6 من طاقم طائرة للتزويد بالوقود سقطت غربي العراق
الجيش الأمريكي: مقتل 4 من أصل 6 من طاقم طائرة للتزويد بالوقود سقطت غربي العراق
 في إطار عمليات يوم القدس.. حزب الله يستهدف تجمعات ومستوطنات الاحتلال الإسرائيلي
في إطار عمليات يوم القدس.. حزب الله يستهدف تجمعات ومستوطنات الاحتلال الإسرائيلي
 إيران تستهدف سفينة CIF التابعة لوكالة الاستخبارات المركزية الأمريكية
إيران تستهدف سفينة CIF التابعة لوكالة الاستخبارات المركزية الأمريكية
 الحرس الثوري: مضيق هرمز سيظل مغلقاً وفق توجيهات المرشد الجديد
الحرس الثوري: مضيق هرمز سيظل مغلقاً وفق توجيهات المرشد الجديد
 السيد مجتبى حسيني خامنئي يصدر البيان الأول: ابطالنا أزالوا من الأعداء وهم السيطرة على وطننا
السيد مجتبى حسيني خامنئي يصدر البيان الأول: ابطالنا أزالوا من الأعداء وهم السيطرة على وطننا
